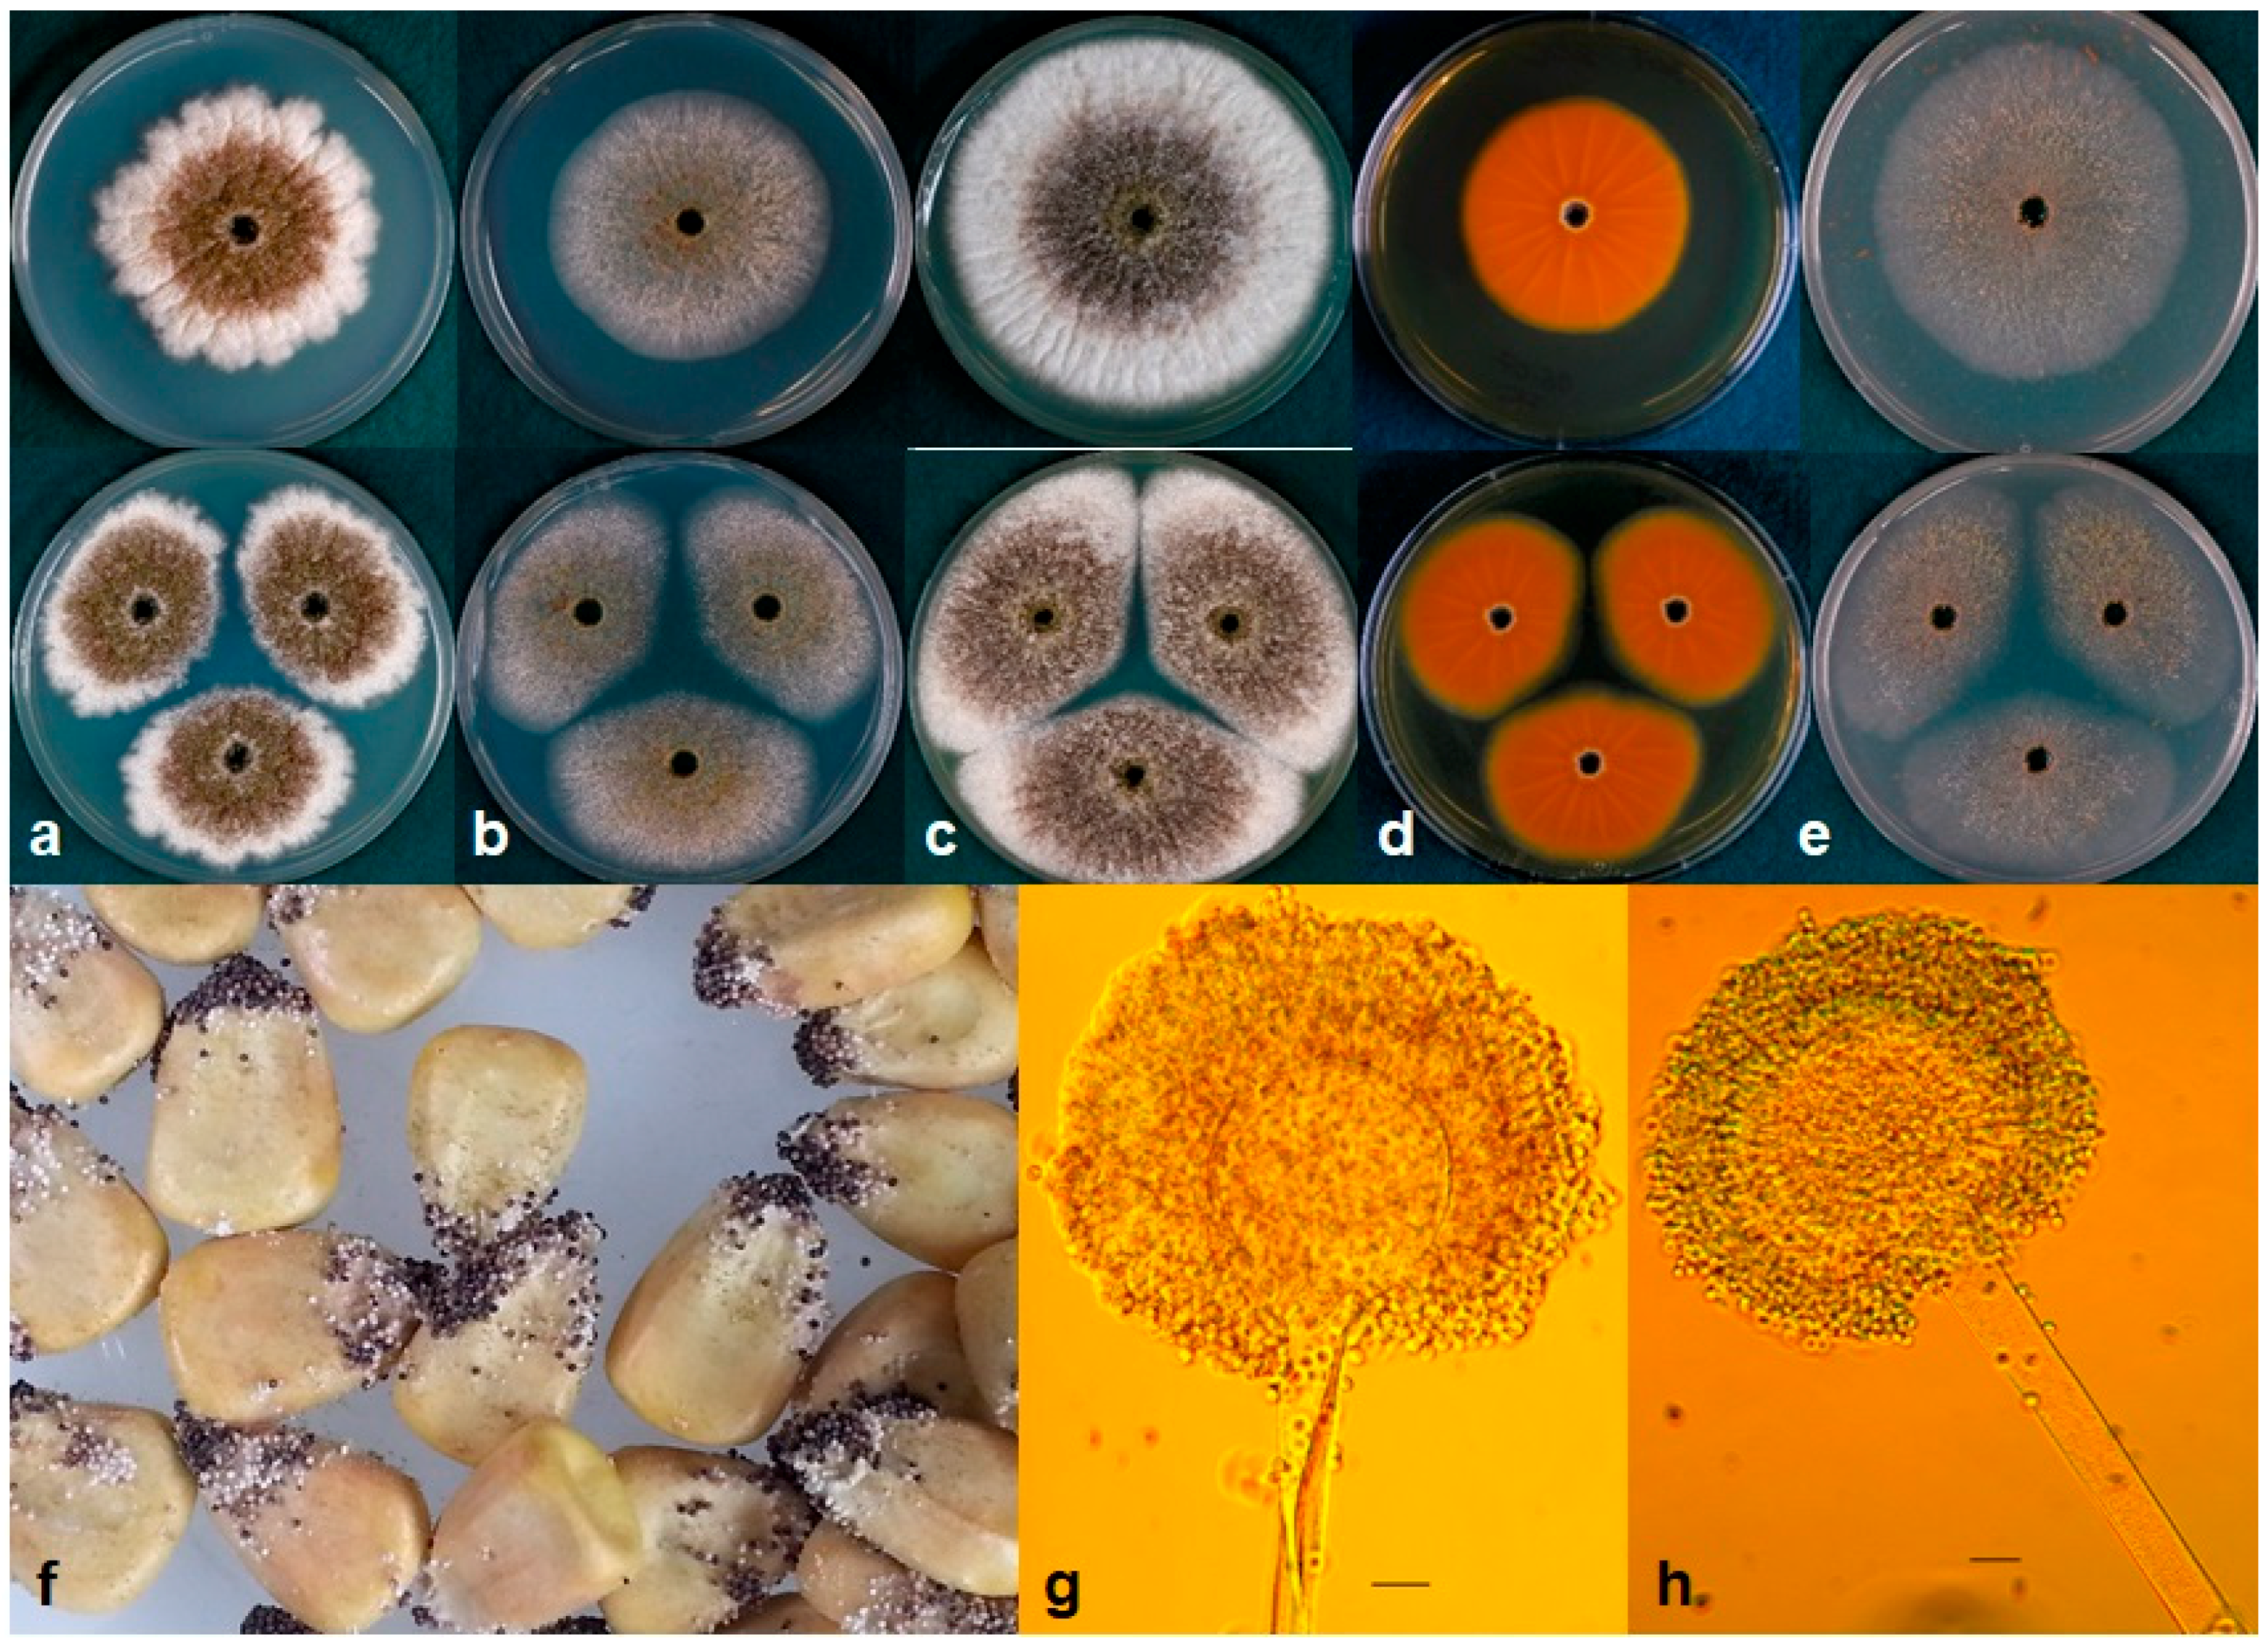
Toxins 10 00513 g002 Toxins 10 00513 g002

Aspergillus texensis: A Novel Aflatoxin Producer with S Morphology from the United States
Abstract
1. Introduction
2. Results
2.1. Molecular Analyses and Phylogenetics
2.2. Aspergillic Acid
2.3. Cyclopiazonic Acid
2.4. Aflatoxins
2.5. Taxonomy
3. Discussion
4. Materials and Methods
4.1. Fungal Isolates and Morphology
4.2. Production of Aspergillic Acid, Aflatoxins, and Cyclopiazonic Acid
4.3. DNA Extraction and PCR Amplifications
4.4. Molecular Analysis and Phylogenetics
4.5. Data Analysis
Supplementary Materials
Author Contributions
Acknowledgments
Conflicts of Interest
References
- Cotty, P.J. Aflatoxin-producing potential of communities of Aspergillus section Flavi from cotton producing areas in the United States. Mycol. Res. 1997, 101, 698–704. [Google Scholar] [CrossRef]
- Donner, M.; Lichtemberg, P.S.; Doster, M.; Picot, A.; Cotty, P.J.; Puckett, R.D.; Michailides, T.J. Community structure of Aspergillus flavus and A. parasiticus in major almond-producing areas of California, United States. Plant Dis. 2015, 99, 1161–1169. [Google Scholar] [CrossRef]
- Kachapulula, P.W.; Akello, J.; Bandyopadhyay, R.; Cotty, P.J. Aspergillus section Flavi community structure in Zambia influences aflatoxin contamination of maize and groundnut. Int. J. Food Microbiol. 2017, 261, 49–56. [Google Scholar] [CrossRef]
- Probst, C.; Bandyopadhyay, R.; Cotty, P.J. Diversity of aflatoxin-producing fungi and their impact on food safety in sub-Saharan Africa. Int. J. Food Microbiol. 2014, 174, 113–122. [Google Scholar] [CrossRef]
- Singh, P.; Cotty, P.J. Aflatoxin contamination of dried red chilies: Contrasts between the United States and Nigeria, two markets differing in regulation enforcement. Food Control 2017, 80, 374–379. [Google Scholar] [CrossRef]
- De Iongh, H.; Vles, R.O.; Van Pelt, J.G. Milk of mammals fed an aflatoxin-containing diet. Nature 1964, 202, 466–467. [Google Scholar] [CrossRef]
- Holzapfel, C.W.; Steyn, P.S.; Purchase, I.F.H. Isolation and structure of aflatoxins M1 and M2. Tetrahedron Lett. 1966, 7, 2799–2803. [Google Scholar] [CrossRef]
- Frisvad, J.C.; Samson, R.A.; Smedsgaard, J. Emericella astellata, a new producer of aflatoxin B1, B2 and sterigmatocystin. Lett. Appl. Microbiol. 2004, 38, 440–445. [Google Scholar] [CrossRef]
- Klich, M.A.; Mullaney, E.J.; Daly, C.B.; Cary, J.W. Molecular and physiological aspects of aflatoxin and sterigmatocystin biosynthesis by Aspergillus tamarii and A. ochraceoroseus. Appl. Microbiol. Biotechnol. 2000, 53, 605–609. [Google Scholar] [CrossRef]
- Cotty, P.J. Aflatoxin contamination of commercial cottonseed caused by the S strain of Aspergillus flavus. Phytopathology 1996, 86, S71. [Google Scholar]
- Ehrlich, K.C.; Kobbeman, K.; Montalbano, B.G.; Cotty, P.J. Aflatoxin-producing Aspergillus species from Thailand. Int. J. Food Microbiol. 2007, 114, 153–159. [Google Scholar] [CrossRef]
- Singh, P.; Cotty, P.J. Characterization of Aspergilli from dried red chilies (Capsicum spp.): Insights into the etiology of aflatoxin contamination. Int. J. Food Microbiol. 2019, 289, 145–153. [Google Scholar] [CrossRef]
- Cotty, P.J.; Probst, C.; Jaime-Garcia, R. Etiology and management of aflatoxin contamination. In Mycotoxins: Detection Methods, Management, Public Health and Agricultural Trade; Leslie, J.F., Bandyopadhyay, R., Visconti, A., Eds.; CAB International: Oxfordshire, UK, 2008; pp. 287–299. [Google Scholar]
- Cardwell, K.F.; Cotty, P.J. Distribution of Aspergillus section Flavi among field soils from the four agroecological zones of the Republic of Benin, West Africa. Plant Dis. 2002, 86, 434–439. [Google Scholar] [CrossRef]
- Donner, M.; Atehnkeng, J.; Sikora, R.A.; Bandyopadhyay, R.; Cotty, P.J. Distribution of Aspergillus section Flavi in soils of maize fields in three agroecological zones of Nigeria. Soil Biol. Biochem. 2009, 41, 37–44. [Google Scholar] [CrossRef]
- Probst, C.; Callicott, K.A.; Cotty, P.J. Deadly strains of Kenyan Aspergillus are distinct from other aflatoxin producers. Eur. J. Plant Pathol. 2012, 132, 419–429. [Google Scholar] [CrossRef]
- Frisvad, J.C.; Hubka, V.; Ezekiel, C.N.; Hong, S.B.; Nováková, A.; Chen, A.J.; Arzanlou, M.; Larsen, T.O.; Sklenář, F.; Mahakarnchanakul, W.; et al. Taxonomy of Aspergillus section Flavi and their production of aflatoxins, ochratoxins and other mycotoxins. Studies Mycol. 2019, 93, 1–63. [Google Scholar] [CrossRef]
- Cotty, P.J.; Jaime-Garcia, R. Influences of climate on aflatoxin producing fungi and aflatoxin contamination. Int. J. Food Microbiol. 2007, 119, 109–115. [Google Scholar] [CrossRef]
- International Agency for Research on Cancer (IARC). Traditional Herbal Medicines, Some Mycotoxins, Naphthalene and Styrene. IARC Monogr. Eval. Carcinog. Risks Hum. 2002, 82, 1–556. [Google Scholar]
- Shephard, G.S. Aflatoxin and food safety: Recent African perspectives. J. Toxicol. Toxin Rev. 2003, 22, 267–286. [Google Scholar] [CrossRef]
- Williams, J.H.; Phillips, T.D.; Jolly, P.E.; Stiles, J.K.; Jolly, C.M.; Aggarwal, D. Human aflatoxicosis in developing countries: A review of toxicology, exposure, potential health consequences, and interventions. Am. J. Clin. Nutr. 2004, 80, 1106–1122. [Google Scholar] [CrossRef]
- Turner, P.C.; Moore, S.E.; Hall, A.J.; Prentice, A.M.; Wild, C.P. Modification of immune function through exposure to dietary aflatoxin in Gambian children. Environ. Health Perspec. 2003, 111, 217–220. [Google Scholar] [CrossRef]
- Gong, Y.Y.; Hounsa, A.; Egal, S.; Turner, P.C.; Sutcliffe, A.E.; Hall, A.J.; Cardwell, K.; Wild, C.P. Postweaning exposure to aflatoxin results in impaired child growth: A longitudinal study in Benin, West Africa. Environ. Health Perspect. 2004, 112, 1334–1338. [Google Scholar] [CrossRef]
- Khlangwiset, P.; Shephard, G.S.; Wu, F. Aflatoxins and growth impairment: A review. Crit. Rev. Toxicol. 2011, 41, 740–755. [Google Scholar] [CrossRef]
- Liu, Y.; Wu, F. Global burden of aflatoxin-induced hepatocellular carcinoma: A risk assessment. Environ. Health Perspect. 2010, 118, 818–824. [Google Scholar] [CrossRef]
- Wang, J.S.; Tang, L. Epidemiology of aflatoxin exposure and human liver cancer. Toxin Rev. 2004, 23, 249–271. [Google Scholar] [CrossRef]
- Centers for Disease Control and Prevention. Outbreak of aflatoxin poisoning—Eastern and central provinces, Kenya, January–July 2004. Morb. Mortal. Wkly. Rep. 2004, 53, 790–793. [Google Scholar]
- Tanzania: Food Poisoning Linked to 14 Deaths in Two Regions. Available online: http://allafrica.com/stories/201607290685.html (accessed on 6 June 2018).
- Aflatoxin Kills 4 Children in Tanzania. Available online: https://www.ippmedia.com/en/news/aflatoxin-kills-4-children-tanzania (accessed on 6 June 2018).
- Robens, J.; Cardwell, K. The costs of mycotoxin management to the USA: Management of aflatoxins in the United States. J. Toxicol. Toxin Rev. 2003, 22, 139–152. [Google Scholar] [CrossRef]
- Cotty, P.J.; Bayman, P.; Egel, D.S.; Elias, K.S. Agriculture, aflatoxins and Aspergillus. In The Genus Aspergillus: From Taxonomy and Genetics to Industrial Application; Powell, K.A., Renwick, A., Perberdy, J.F., Eds.; Plenum Press: New York, NY, USA, 1994; pp. 1–27. [Google Scholar]
- Cotty, P.J. Virulence and cultural characteristics of two Aspergillus flavus strains pathogenic on cotton. Phytopathology 1989, 79, 808–881. [Google Scholar] [CrossRef]
- Jaime-Garcia, R.; Cotty, P.J. Crop rotation and soil temperature influence the community structure of Aspergillus flavus in soil. Soil Biol. Biochem. 2010, 42, 1842–1847. [Google Scholar] [CrossRef]
- Carvajal-Campos, A.; Manizan, A.L.; Tadrist, S.; Akaki, D.K.; Koffi-Nevry, R.; Moore, G.G.; Fapohunda, S.O.; Bailly, S.; Montet, D.; Oswald, I.P.; et al. Aspergillus korhogoensis, a Novel Aflatoxin Producing Species from the Côte d’Ivoire. Toxins 2017, 9, 353. [Google Scholar] [CrossRef]
- Peterson, S.W.; Ito, Y.; Horn, B.W.; Goto, T. Aspergillus bombycis, a new aflatoxigenic species and genetic variation in its sibling species, A. nomius. Mycologia 2001, 93, 689–703. [Google Scholar] [CrossRef]
- Ito, Y.; Peterson, S.W.; Wicklow, D.T.; Goto, T. Aspergillus pseudotamarii, a new aflatoxin producing species in Aspergillus section Flavi. Mycol. Res. 2001, 105, 233–239. [Google Scholar] [CrossRef]
- Kurtzman, C.P.; Horn, B.W.; Hesseltine, C.W. Aspergillus nomius, a new aflatoxin-producing species related to Aspergillus flavus and Aspergillus tamarii. Antonie van leeuwenhoek 1987, 53, 147–158. [Google Scholar] [CrossRef]
- Horn, B.W. Aspergillus caelatus, a new species in section Flavi. Mycotaxon 1997, 61, 185–191. [Google Scholar]
- Wei, D.L.; Jong, S.C. Production of aflatoxins by strains of the Aspergillus flavus group maintained in ATCC. Mycopathologia 1986, 93, 19–24. [Google Scholar] [CrossRef]
- Rambo, G.W.; Tuite, J.; Crane, P. Preharvest inoculation and infection of dent corn ears with Aspergillus flavus and Aspergillus parasiticus. Phytopathology 1974, 64, 797–800. [Google Scholar] [CrossRef]
- Hesseltine, C.W.; Shotwell, O.L.; Smith, M.; Ellis, J.J.; Vandegraft, E.; Shannon, G. Production of Various Aflatoxins by Strains of the Aspergillus flavus Series; Kluwer Academic Publishers: Dordrecht, The Netherlands, 1970; pp. 202–210. [Google Scholar]
- Pildain, M.B.; Frisvad, J.C.; Vaamonde, G.; Cabral, D.; Varga, J.; Samson, R.A. Two novel aflatoxin-producing Aspergillus species from Argentinean peanuts. Int. J. Syst. Evol. Microbiol. 2008, 58, 725–735. [Google Scholar] [CrossRef]
- Geiser, D.M.; Pitt, J.I.; Taylor, J.W. Cryptic speciation and recombination in the aflatoxin-producing fungus Aspergillus flavus. Proc. Natl. Acad. Sci. USA 1998, 95, 388–393. [Google Scholar] [CrossRef]
- Probst, C.; Njapau, H.; Cotty, P.J. Outbreak of an acute aflatoxicosis in Kenya in 2004: Identification of the causal agent. Appl. Environ. Microbiol. 2007, 73, 2762–2764. [Google Scholar] [CrossRef]
- Cotty, P.J.; Cardwell, K.F. Divergence of West African and North American Communities of Aspergillus section Flavi. Appl. Environ. Microbiol. 1999, 65, 2264–2266. [Google Scholar]
- Saito, M.; Tsuruta, O. A new variety of Aspergillus flavus from tropical soil in Thailand and its aflatoxin productivity. Proc. Jpn. Assoc. Mycotoxicol. 1993, 1993, 31–36. [Google Scholar] [CrossRef][Green Version]
- Samson, R.A.; Varga, J. What is a species in Aspergillus? Med. Mycol. 2009, 47, S13–S20. [Google Scholar] [CrossRef]
- Soares, C.; Rodrigues, P.; Peterson, S.W.; Lima, N.; Venâncio, A. Three new species of Aspergillus section Flavi isolated from almonds and maize in Portugal. Mycologia 2012, 104, 682–697. [Google Scholar] [CrossRef]
- Peterson, S.W. Phylogenetic analysis of Aspergillus species using DNA sequences from four loci. Mycologia 2008, 100, 205–226. [Google Scholar] [CrossRef]
- Glass, N.L.; Donaldson, G.C. Development of primer sets designed for use with the PCR to amplify conserved genes from filamentous ascomycetes. Appl. Environ. Microbiol. 1995, 61, 1323–1330. [Google Scholar]
- Ehrlich, K.C.; Chang, P.K.; Yu, J.; Cotty, P.J. Aflatoxin biosynthesis cluster gene cypA is required for G aflatoxin formation. Appl. Environ. Microbiol. 2004, 70, 6518–6524. [Google Scholar] [CrossRef]
- Bayman, P.; Cotty, P.J. Vegetative compatibility and genetic diversity in the Aspergillus flavus population of a single field. Can. J. Bot. 1991, 69, 1707–1711. [Google Scholar] [CrossRef]
- Boyd, M.L.; Cotty, P.J. Aspergillus flavus and aflatoxin contamination of leguminous trees of the Sonoran Desert in Arizona. Phytopathology 2001, 91, 913–919. [Google Scholar] [CrossRef]
- Jaime-Garcia, R.; Cotty, P.J. Aspergillus flavus in soils and corncobs in south Texas: Implications for management of aflatoxins in corn-cotton rotations. Plant Dis. 2004, 88, 1366–1371. [Google Scholar] [CrossRef]
- Horn, B.W.; Greene, R.L.; Dorner, J.W. Effect of corn and peanut cultivation on soil populations of Aspergillus flavus and A. parasiticus in southwestern Georgia. Appl. Environ. Microbiol. 1995, 61, 2472–2475. [Google Scholar]
- Tubajika, K.M.; Mascagni, H.J.; Damann, K.E.; Russin, J.S. Nitrogen fertilizer influence on aflatoxin contamination of corn in Louisiana. J. Agric. Food Chem. 1999, 47, 5257–5260. [Google Scholar] [CrossRef]
- King, J.M.; Walker, T.; Njapau, H.; Park, D.L.; Damann, K.E. Managing aflatoxin contamination in corn: Scientists use integrated approach to solution. Louisiana Agric. 2000, 43, 20–21. [Google Scholar]
- Aflatoxin Prevention. Arkansas Corn and Grain Sorghum Board. Available online: http://www.corn-sorghum.org/aflatoxin-prevention-0.html (accessed on 14 June 2018).
- Jaime-Garcia, R.; Cotty, P.J. Aflatoxin contamination of commercial cottonseed in south Texas. Phytopathology 2003, 93, 1190–1200. [Google Scholar] [CrossRef]
- Jaime-Garcia, R.; Cotty, P.J. Spatial relationships of soil texture and crop rotation to Aspergillus flavus community structure in South Texas. Phytopathology 2006, 96, 599–607. [Google Scholar] [CrossRef]
- Adye, J.A.R.I.M.; Mateles, R.I. Incorporation of labelled compounds into aflatoxins. Biochim. Biophys. Acta Gen. Subj. 1964, 86, 418–420. [Google Scholar] [CrossRef]
- Pitt, J.I.; Hocking, A.D.; Glenn, D.R. An improved medium for the detection of Aspergillus flavus and A. parasiticus. J. Appl. Microbiol. 1983, 54, 109–114. [Google Scholar] [CrossRef]
- Probst, C.; Cotty, P.J. Relationships between in vivo and in vitro aflatoxin production: Reliable prediction of fungal ability to contaminate maize with aflatoxins. Fungal Biol. 2012, 116, 503–510. [Google Scholar] [CrossRef]
- Lansden, J.A. Determination of cyclopiazonic acid in peanuts and corn by thin layer chromatography. J. Assoc. Off. Anal. Chem. 1986, 69, 964–966. [Google Scholar]
- Chang, P.K.; Horn, B.W.; Dorner, J.W. Sequence breakpoints in the aflatoxin biosynthesis gene cluster and flanking regions in nonaflatoxigenic Aspergillus flavus isolates. Fungal Genet. Biol. 2005, 42, 914–923. [Google Scholar] [CrossRef]
- Callicott, K.A.; Cotty, P.J. Method for monitoring deletions in the aflatoxin biosynthesis gene cluster of Aspergillus flavus with multiplex PCR. Lett. Appl. Microbiol. 2015, 60, 60–65. [Google Scholar] [CrossRef]
- Koressaar, T.; Remm, M. Enhancements and modifications of primer design program Primer3. Bioinformatics 2007, 23, 1289–1291. [Google Scholar] [CrossRef]
- Untergasser, A.; Cutcutache, I.; Koressaar, T.; Ye, J.; Faircloth, B.C.; Remm, M.; Rozen, S.G. Primer3—New capabilities and interfaces. Nucleic Acids Res. 2012, 40, e115. [Google Scholar] [CrossRef]
- Ramirez-Prado, J.H.; Moore, G.G.; Horn, B.W.; Carbone, I. Characterization and population analysis of the mating-type genes in Aspergillus flavus and Aspergillus parasiticus. Fungal Genet. Biol. 2008, 45, 1292–1299. [Google Scholar] [CrossRef]
- Huelsenbeck, J.P.; Ronquist, F. MrBayes: Bayesian inference of phylogeny. Bioinformatics 2001, 17, 754–755. [Google Scholar] [CrossRef] [PubMed]
- Dereeper, A.; Guignon, V.; Blanc, G.; Audic, S.; Buffet, S.; Chevenet, F.; Dufayard, J.F.; Guindon, S.; Lefort, V.; Lescot, M.; et al. Phylogeny. fr: Robust phylogenetic analysis for the non-specialist. Nucleic Acids Res. 2008, 36, W465–W469. [Google Scholar] [CrossRef] [PubMed]
- Dereeper, A.; Audic, S.; Claverie, J.M.; Blanc, G. BLAST-EXPLORER helps you building datasets for phylogenetic analysis. BMC Evol. Biol. 2010, 10, 8. [Google Scholar] [CrossRef]
- Rambaut, A. FigTree v1. 4. 2012. Available online: http://tree.bio.ed.ac.uk/ (accessed on 30 March 2018).

| Isolate # | Species/Taxon | Source | Citation |
|---|---|---|---|
| NRRL 13137 | A. nomius | Wheat, USA | [37] |
| NRRL 443 | A. pseudotamarii | Argentina | [36] |
| NRRL 25528 | A. caelatus | Soil, USA | [38] |
| NRRL 465 | A. parasiticus | USA | [39] |
| NRRL 29538 | A. parasiticus | Soil, Georgia, USA | Horn B.W., National Peanut Lab, Dawson, GA (in NRRL database) |
| NRRL 29590 | A. parasiticus | Soil, Georgia, USA | Horn B.W., National Peanut Lab, Dawson, GA (in NRRL database) |
| NRRL 424 | A. parasiticus | Soil, Georgia, USA | Scales F.M. (in NRRL database) |
| NRRL 2999 | A. parasiticus | Peanut, Uganda | [40] |
| BN009-E | A. parasiticus | Soil, Benin | None |
| NRRL A-11611 | A. minisclerotigenes | Soil, Nigeria | [41,42] |
| 4-2 | A. minisclerotigenes | Soil, Australia | [43] |
| TAR3N43 | A. minisclerotigenes | Peanut, Argentina | [16] |
| AF70/ATCC MYA-384 | A. flavus S Morphotype | Soil, Arizona, USA | [32] |
| AF42/ATCC MYA-383 | A. flavus S Morphotype | Soil, Arizona, USA | [32] |
| AF12/ATCC MYA-382 | A. flavus S Morphotype | Soil, Arizona, USA | [32] |
| NRRL 3251 | A. flavus S Morphotype | Walnut, California, USA | [41] |
| AF13/ATCC 96044 | A. flavus L Morphotype | Soil, Arizona, USA | [32] |
| CHL019 | A. flavus L Morphotype | Chili | [12] |
| CHL159 | A. flavus L Morphotype | Chili | [12] |
| CHL187 | A. flavus L Morphotype | Chili, Pakistan | [12] |
| W11P1R3-B R/NRRL 66855/A2292 | A. texensis | Soil, Texas, USA | Current Study |
| EC42-I/NRRL 66856/A2295 | A. texensis | Maize, Texas, USA | Current Study |
| BRG3224-E/NRRL 66857/A2296 | A. texensis | Maize, Louisiana, USA | Current Study |
| WXMX1-1G/NRRL 66858/A2294 | A. texensis | Soil, Texas, USA | Current Study |
| VCSSBC1-I/NRRL 66859/A2293 | A. texensis | Maize, Arkansas, USA | Current Study |
| J35-E | A. texensis | Soil, Texas, USA | Current Study |
| VC16-A | A. texensis | Maize, Texas, USA | Current Study |
| CTL-1I | A. texensis | Soil, Texas, USA | Current Study |
| P2R2-A Q | A. texensis | Soil, Texas, USA | Current Study |
| 1-1-O | A. texensis | Soil, Texas, USA | Current Study |
| 1-1L | A. texensis | Soil, Texas, USA | Current Study |
| K805-E/A1170 | Lethal Aflatoxicosis Fungus | Maize, Kenya | [44] |
| K784-D/A1168 | Lethal Aflatoxicosis Fungus | Maize, Kenya | [44] |
| NRRL A-11612 | A. aflatoxiformans | Groundnut, Nigeria | [17,41] |
| BN040-B/ATCC MYA-381 | A. aflatoxiformans | Soil, Benin | [17,45] |
| BN038-G/ATCC MYA-380 | A. aflatoxiformans | Soil, Benin | [17,45] |
| BN008-R/ATCC MYA-379 | A. aflatoxiformans | Soil, Benin | [17,45] |
| Species | Aflatoxin B1 | Aflatoxin B2 | Aflatoxin G1 | Aflatoxin G2 | CPA | Aspergillic Acid |
|---|---|---|---|---|---|---|
| A. texensis | + | + | + | + | + | + |
| A. flavus | + | + | − | − | ± | + |
| A. minisclerotigenes | + | + | + | + | + | + |
| A. parasiticus | + | + | + | + | − | + |
| Species | Isolate | Source/Location | Aflatoxin (µg/g) | ||
|---|---|---|---|---|---|
| AFB | AFG | Total AF | |||
| A. texensis | BRG3224 E | Maize/USA | 42 | 111 | 153 |
| EC42-I | Maize/USA | 40 | 99 | 139 | |
| W11P1R3-B R | Soil/USA | 47 | 111 | 158 | |
| Average | 43C | 107B | 150B | ||
| A. flavus S Morphotype | AF12 | Soil/USA | 190 | NA | 190 |
| AF42 | Soil/USA | 181 | NA | 181 | |
| AF70 | Soil/USA | 191 | NA | 191 | |
| Average | 187AB | NA* | 187B | ||
| A. minisclerotigenes | A-11611 | Groundnut/Nigeria | 31x | 72x | 103x |
| 4-2 | Soil/Australia | 9y | 24y | 33y | |
| TAR3N43 | Soil/Argentina | 9y | 25y | 34y | |
| Average | 17D | 40C | 57C | ||
| A. aflatoxiformans | A-11612 | Groundnut/Nigeria | 92y | 202y | 294y |
| BN038-G | Soil/Benin | 105y | 129z | 234y | |
| BN040-B | Soil/Benin | 207x | 361x | 568x | |
| Average | 134B | 231A | 365A | ||
| Lethal Aflatoxicosis Fungus | K805-E | Maize/Kenya | 304 | NA | 304xy |
| K784-D | Maize/Kenya | 361 | NA | 361x | |
| K849-B | Maize/Kenya | 215 | NA | 215y | |
| Average | 294A | NA* | 294A | ||
| Medium Φ | Species | Colony Diameter (mm) ρ | |||||||
|---|---|---|---|---|---|---|---|---|---|
| 15 °C | 20 °C | 25 °C | 30 °C | 35 °C | 37 °C | 40 °C | 42 °C | ||
| CZ | A. texensis | 3b | 31b | 53ab | 67 | 73 | 55b | 46 | 7 |
| A. flavus | 7a | 35b | 50b | 66 | 65 | 54b | 37 | 8 | |
| A. minisclerotigenes | 3b | 41a | 62a | 75 | 75 | 63a | 39 | 8 | |
| CZ with NaCl | A. texensis | 11 | 44 | 60 | 72 | 77 | 72 | 68 | 13 |
| A. flavus | 12 | 44 | 57 | 69 | 71 | 65 | 69 | 12 | |
| A. minisclerotigenes | 10 | 44 | 66 | 73 | 77 | 72 | 73 | 15 | |
| CYA | A. texensis | 9 | 46 | 71 | 77 | 78 | 65 | 54 | 9 |
| A. flavus | 11 | 42 | 64 | 72 | 71 | 57 | 56 | 11 | |
| A. minisclerotigenes | 9 | 44 | 68 | 77 | 78 | 64 | 49 | 10 | |
| Malt | A. texensis | 7a | 30 | 46ab | 68 | 69 | 55 | 41 | 11 |
| A. flavus | 5ab | 34 | 44b | 57 | 67 | 55 | 30 | 7 | |
| A. minisclerotigenes | 3b | 43 | 69a | 67 | 68 | 58 | 32 | 8 | |
| V8 | A. texensis | 4a | 33 | 60 | 68 | 72 | 52b | 42a | 7 |
| A. flavus | 3ab | 32 | 53 | 66 | 68 | 61a | 28b | 7 | |
| A. minisclerotigenes | 2b | 31 | 59 | 74 | 73 | 67a | 31b | 9 | |
| Primer Pair | Target Gene | Sequence | Ta (°C) | Reference |
|---|---|---|---|---|
| Bt2a-2b | β-tubulin | F-GGTAACCAAATCCGTGCTGCTTTC | 51 | [50] |
| R-ACCCTCAGTGTAGTGACCCTTGGC | ||||
| Bt3a-3b | F-CGTCGTTCATTCGAGGTGTA | 56 | Current study | |
| R-CCGCTCAACTTCAAGTCCAT | ||||
| cmd42-637 | Calmodulin | F-GGCCTTCTCCCTATTCGTAA | 56 | [16] |
| R-CTCGCGGATCATCTCATC | ||||
| cmd2F-2R | F-GGCTGGATGTGTGTAAATC | 48 | [16] | |
| R-ATTGGTCGCATTTGAAGGG | ||||
| niaDF-AR | Nitrate reductase | F-CGGACGATAAGCAACAACAC | 52 | [16] |
| R-GGATGAACACCCGTTAATCTGA | ||||
| niaDBF-BR | F-ACGGCCGACAGAAGTGCTGA | 57 | [16] | |
| R-TGGGCGAAGAGACTCCCCGT | ||||
| niaDCF-CR | F-GCAGCCCAATGGTCACTACGGC | 55 | [12] | |
| R-GGCTGCACGCCCAATGCTTC |
© 2018 by the authors. Licensee MDPI, Basel, Switzerland. This article is an open access article distributed under the terms and conditions of the Creative Commons Attribution (CC BY) license (http://creativecommons.org/licenses/by/4.0/).
Share and Cite
Singh, P.; Orbach, M.J.; Cotty, P.J. Aspergillus texensis: A Novel Aflatoxin Producer with S Morphology from the United States. Toxins 2018, 10, 513. https://doi.org/10.3390/toxins10120513
Singh P, Orbach MJ, Cotty PJ. Aspergillus texensis: A Novel Aflatoxin Producer with S Morphology from the United States. Toxins. 2018; 10(12):513. https://doi.org/10.3390/toxins10120513
Chicago/Turabian StyleSingh, Pummi, Marc J. Orbach, and Peter J. Cotty. 2018. "Aspergillus texensis: A Novel Aflatoxin Producer with S Morphology from the United States" Toxins 10, no. 12: 513. https://doi.org/10.3390/toxins10120513
APA StyleSingh, P., Orbach, M. J., & Cotty, P. J. (2018). Aspergillus texensis: A Novel Aflatoxin Producer with S Morphology from the United States. Toxins, 10(12), 513. https://doi.org/10.3390/toxins10120513
